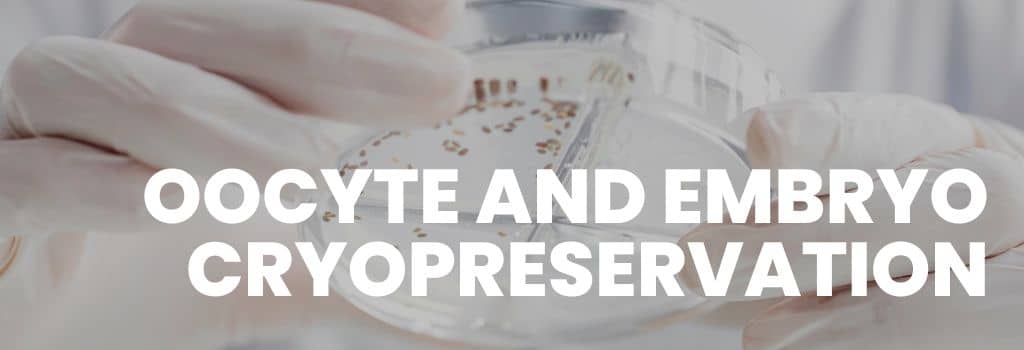
Egg & Embryo Freezing in Delhi NCR | Fertijoy IVF Center

FertiJoy IVF & Fertility
Building families beyond borders
Oocyte and Embryo cryopreservation
Oocyte and Embryo cryopreservation
At Fertijoy IVF Center in Delhi NCR, we offer specialized oocyte (egg) and embryo cryopreservation services to help individuals and couples preserve their fertility for future family planning. Cryopreservation is a safe, proven, and highly effective method of freezing eggs and embryos at ultra-low temperatures, maintaining their quality and viability for years.
Oocyte Cryopreservation (Egg Freezing)
Egg freezing is an excellent option for women who wish to delay pregnancy due to career, personal choices, or medical reasons such as cancer treatment. Fertijoy uses advanced vitrification techniques to ensure high survival rates, providing women with the freedom to preserve their reproductive potential confidently.
Embryo Cryopreservation
Embryo freezing is commonly recommended for couples undergoing IVF treatments who wish to store additional healthy embryos for future cycles or family planning. Fertijoy’s state-of-the-art cryostorage facilities guarantee the safe, long-term preservation of embryos with strict quality and security protocols.
Our expert fertility specialists, embryologists, and counselors provide step-by-step guidance throughout the process, from initial consultation and hormonal stimulation to egg retrieval, fertilization, freezing, and storage. We offer compassionate care and personalized treatment plans tailored to each patient’s reproductive goals.
Choose Fertijoy IVF Center’s oocyte and embryo cryopreservation services in Delhi NCR to secure your path to parenthood with world-class technology, trusted expertise, and patient-centric care.
Tags
- Oocyte Cryopreservation
- Egg Freezing
- Embryo Cryopreservation
- Fertility Preservation
- Fertijoy IVF
- Future Family Planning
- IVF Delhi
- Best IVF Clinic
- Delhi NCR IVF
- Cryopreservation